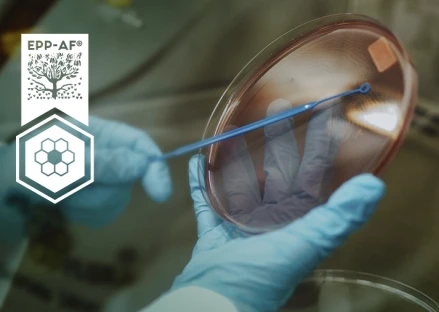

Pesquisa

Todos os extratos de própolis são iguais? Isso poderá surpreender você, mas a resposta é “não”.
Isso porque existem muitas variáveis que influenciam no tipo e na qualidade de própolis, como clima, flora, variedade de abelhas, além dos diferentes processos utilizados para produzir um extrato de própolis.
O EPP-AF® é diferente! Inovador e exclusivo, o extrato padronizado de própolis da Apis Flora é o único produto à base de própolis existente no mercado química e biologicamente caracterizado e com eficácia e segurança pré-clínica e clínica estabelecidas, o que garante a excelência em termos de produto natural.

Um extrato padronizado é garantia de sempre conter o teor correto de bioativos da própolis em todos os lotes produzidos. Como a própolis tem mais de 300 compostos, o extrato padronizado garante as quantidades necessárias daqueles bioativos que você precisa para usufruir dos benefícios da própolis para sua saúde.
Muitas pesquisas científicas já foram e são realizadas com própolis, apresentando muitos resultados de eficácia e segurança; porém, cada uma foi feita utilizando uma própolis diferente ou preparada de forma diferente. Com isso, nem sempre é possível sabermos se vamos ter os mesmos resultados da pesquisa com os extratos de própolis vendidos no mercado.
Daí a grande importância de se ter uma “fórmula especial” para o extrato de própolis, com uma composição reprodutível e com um processo produtivo padronizado. Uma vez obtida essa tecnologia, nossa equipe estudou integralmente, sob todos os enfoques, sua segurança e a eficácia, não só em modelos experimentais, mas também por meio de pesquisas clínicas realizadas em renomadas instituições brasileiras e com eminentes pesquisadores.

Você sabia que tem muito pouca gente no mundo que já fez estudos clínicos com a própolis?
Nosso centro de pesquisas e inovação, em parceria com diferentes universidades brasileiras, como a USP, UNESP e UNICAMP, dentre outras, desenvolveu o Extrato Padronizado de Própolis, chamado de EPP-AF®. E com esse extrato, a Apis Flora já realizou mais de 5 estudos clínicos de segurança e eficácia.
Nossas pesquisas resultaram no depósito de pedido de patente, junto ao Instituto Nacional de Propriedade Intelectual (INPI, n° PI0405483-0) em 01/02/2005.

A produção do EPP-AF® segue uma tecnologia inovadora e um padrão de qualidade de excelência, que garantem reprodutibilidade, segurança e eficácia a toda linha de produtos à base de própolis da Apis Flora, lote a lote, completamente diferente de tudo que já existe no segmento. Isso significa que as características químicas dos bioativos presentes no produto final são sempre as mesmas, bem como suas propriedades biológicas, o que confere a esse produto qualidade e excelência inigualáveis.
O EPP-AF® é uma matéria-prima essencialmente obtida por uma formulação e um processo de extração exclusivos. A partir desse extrato padronizado, muitas outras formas de apresentação foram posteriormente desenvolvidas e para cada uma há indicação de melhor aplicação. Em outras palavras, para cada produto, finalidade ou via de administração, a Apis Flora tem uma versão do EPP-AF® mais adequada.
Durante alguns anos de pesquisa, a equipe de pesquisadores da Apis Flora mapeou química e biologicamente uma grande parcela das própolis obtidas em todo o Brasil. Isso foi feito após intenso trabalho de desenvolvimento e validação de métodos analíticos que pudessem detectar e quantificar as substâncias ativas presentes na própolis, um verdadeiro Raio X da própolis.

Para você ter uma ideia, já foram descobertas mais de 300 substâncias ativas da própolis! Impressionante, não é?
Imagine quanto tempo e trabalho já foram dedicados para desvendar a própolis.
Além desse mapeamento químico de centenas de amostras de todo o Brasil, nosso grupo também selecionou essas amostras por meio da comparação de suas atividades biológicas, como a atividade antimicrobiana e anti-inflamatória. Ou seja, nossa equipe desenvolveu a fórmula especial do EPP-AF® considerando marcadores químicos e resultados de atividades biológicas de própolis do Brasil todo e, assim, foi possível a composição da fórmula secreta do nosso Extrato Padronizado de Própolis EPP-AF®.

Muito boa pergunta! A Apis Flora leva seu padrão de qualidade muito a sério. Por isso, as matérias-primas que são recebidas na empresa são analisadas frente a todos os parâmetros químicos e biológicos. Com isso, toda matéria-prima que chega recebe seu “RG”, que contém sua impressão digital completa e isso vai para um banco de dados. O sistema usa essas informações para buscar as quantidades e os lotes corretos para compor a formulação do futuro lote, de modo que os requisitos de reprodutibilidade químicos e biológicos sejam totalmente atendidos.
Para se ter uma ideia, entre a chegada da própolis bruta das colmeias e a liberação do produto para venda, são feitas mais de 100 análises laboratoriais.

1985
A Apis Flora produz o primeiro extrato de própolis no Brasil.

1990
Conclusão dos estudos sobre as diferentes própolis do Brasil.

1995
Primeira parceria acadêmica, entre Apis Flora e a Universidade de São Paulo (USP).

1999
A Apis Flora, em parceria com a Universidade de São Paulo (USP), promove o I Simpósio Brasileiro sobre Própolis e Apiterápicos.

2000
Primeiro artigo científico da Apis Flora é publicado: "Atividade anti-inflamatória, antiúlcera gástrica e toxicidade subcrônica do extrato etanólico de própolis".

2001
Com ajuda da Apis Flora, são publicados os Regulamentos de Identidade e Qualidade da Própolis pelo Ministério da Agricultura.

2005
Nasce o EPP-AF®! "Processo de obtenção do extrato padronizado de própolis, extrato assim obtido, suas formulações, produtos e usos". Depósito de patente sob o número PI0405483-0, publicado na Revista de Propriedade Industrial n. 1778, de 01/02/2005.

2007
Primeira pesquisa clínica com o Extrato de Própolis EPP-AF® concluída: "Pesquisa clínica de um gel termorreversível contendo extrato padronizado de própolis (EPP-AF®) para a redução do tempo de cicatrização de lesões em pacientes queimados".

2009
Segunda patente do EPP-AF® depositada: "Gel termorreversível de liberação sustentada contendo extrato padronizado de própolis (EPP-AF®) e respectivo processo de fabricação, com atividade antisséptica e cicatrizante para tratamento de queimaduras, lesões de pele e outros". Depósito de patente sob número PI 0806114-9, publicado na Revista de Propriedade Industrial n. 2017, de 01/09/2009.

2011
Terceira patente do EPP-AF® depositada: "Biocurativo de liberação sustentada obtido a partir de biocelulose e extrato padronizado de própolis (EPP-AF®), bem como seu processo de obtenção e aplicações terapêuticas". Depósito de patente sob n. provisório 018110000672, de 12/01/2011.

2013
Pesquisa clínica para avaliação de segurança clínica e atividade anti-inflamatória do Extrato de Própolis EPP-AF®.
2015
Quarta patente do EPP-AF® depositada: "Processo de obtenção de micropartículas matriciais de extrato padronizado de própolis (EPP-AF®), formulações e seus usos". Depósito de patente sob número BR 1020150330391, de 30/12/2015.

2017
Pesquisa clínica com o uso do Extrato de Própolis EPP-AF® para demonstração de efeito antiproteinúrico em doença renal crônica.

2019
Pesquisa clínica com o uso do Extrato de Própolis EPP-AF® para tratamento de candidíase vaginal.
E nossas pesquisas continuam e continuarão sem interrupção,
pois pesquisas científicas estão no DNA da Apis Flora.